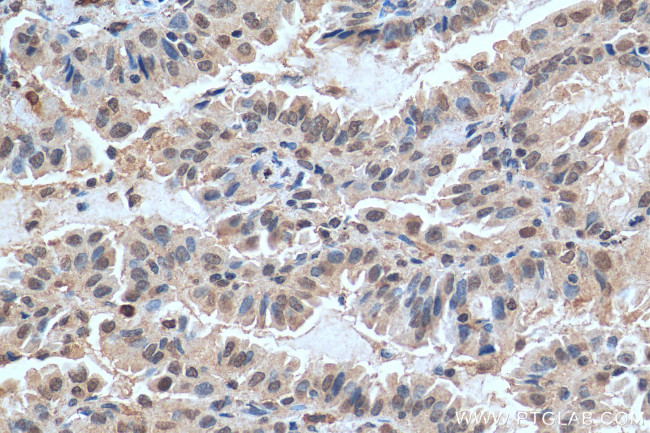
FAM111B Antibody in Immunohistochemistry (Paraffin) (IHC (P))

Search
Proteintech
FAM111B Polyclonal Antibody
{{$productOrderCtrl.translations['antibody.pdp.commerceCard.promotion.promotions']}}
{{$productOrderCtrl.translations['antibody.pdp.commerceCard.promotion.viewpromo']}}
{{$productOrderCtrl.translations['antibody.pdp.commerceCard.promotion.promocode']}}: {{promo.promoCode}} {{promo.promoTitle}} {{promo.promoDescription}}. {{$productOrderCtrl.translations['antibody.pdp.commerceCard.promotion.learnmore']}}
产品信息
29407-1-AP
种属反应
宿主/亚型
分类
类型
抗原
偶联物
形式
浓度
规格
纯化类型
保存液
内含物
保存条件
运输条件
产品详细信息
Aliquoting is unnecessary for -20°C storage.
靶标信息
FAM111B is a 734 amino acid protein that is encoded by a gene that maps to human chromosome 11, which makes up around 4% of human genomic DNA and isconsidered a gene and disease association dense chromosome.The chromosome 11 encoded Atmgene isimportant for regulation ofcellcycle arrest and apoptosisfollowing double strand DNA breaks. Atmmutation leads to the disorderknown as ataxia-telangiectasia. The blood disorders Sickle cell anemia and beta thalassemia are caused by HBB genemutations. Wilms' tumors, WAGR syndrome and Denys-Drash syndrome are associatedwithmutations of the WT1 gene. Jervell and Lange-Nielsen syndrome, Jacobsen syndrome, Niemann-Pick disease, hereditary angioedema and Smith-Lemli-Opitz syndrome are also associatedwith defectsin chromosome 11.
仅用于科研。不用于诊断过程。未经明确授权不得转售。
生物信息学
蛋白别名: Cancer-associated nucleoprotein; CANP; family with sequence similarity 111 member B; Serine protease FAM111B; unnamed protein product
基因别名: CANP; FAM111B; POIKTMP
UniProt ID: (Human) Q6SJ93
Entrez Gene ID: (Human) 374393